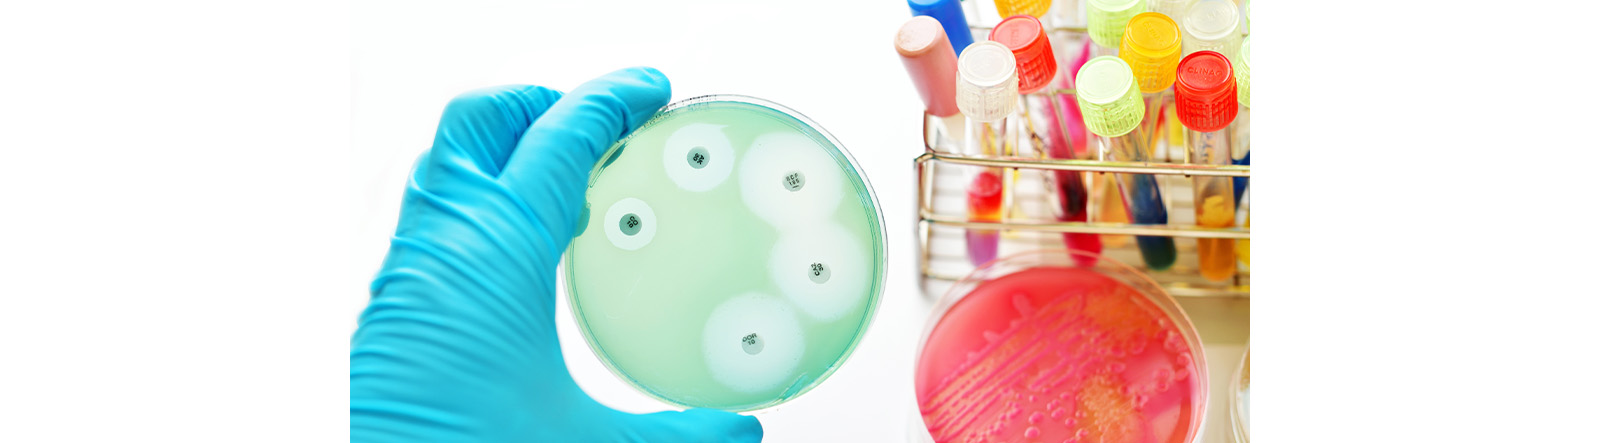

We use cookies, including cookies from third parties, to enhance your user experience and the effectiveness of our marketing activities. These cookies are performance, analytics and advertising cookies, please see our Privacy and Cookie policy for further information. If you agree to all of our cookies select “Accept all” or select “Cookie Settings” to see which cookies we use and choose which ones you would like to accept.
Ensuring Product Hygiene: Key Antimicrobial Testing Methods

What is the antimicrobial test method?
An antimicrobial test is designed to evaluate the antimicrobial performance of a product. Antimicrobial tests are broadly divided into antibacterial tests and antifungal tests, and a product must exhibit excellent performance in both tests to be considered to have antimicrobial performance. These antimicrobial tests vary depending on the type of product being tested, so without expert assistance, one might choose an inappropriate test and obtain incorrect results.

ISO 22196
This test method can be applied to products with hard, non-porous surfaces such as plastics and rubber. A 5cm x 5cm sample is inoculated with a bacterial solution, covered with a thin film, and bacterial growth is assessed after 24 hours. This test provides a quantitative assessment of antibacterial properties, specifically targeting bacteria responsible for discoloration or odor in products. It is highly applicable for use on a wide range of non-porous materials.
ISO 20743
This is the most representative method for evaluating the antibacterial properties of textiles. Approximately 0.4g of fabric is inoculated with a bacterial solution, and the bacterial growth is evaluated after 18 hours. This test provides a quantitative assessment of antibacterial properties, specifically targeting bacteria responsible for discoloration or odor in products. It is designed for absorbent products like textiles, which are difficult to evaluate using ISO 22196.

ASTM G21
This is an antifungal test used for products with hard, non-porous surfaces such as plastics and rubber. A 5cm x 5cm specimen is placed on an agar plate, and a mixed fungal suspension containing five types of fungi is sprayed onto it. The fungal growth is evaluated after 28 days. Although it cannot be quantitatively evaluated, the area of fungal growth on the specimen surface is measured, and the results are reported from Lv.0 to Lv.4.
AATCC 30
This is an antifungal test used for textile products. A specimen with a diameter of 3.8cm is placed on an agar plate, and a single type of fungus is evenly inoculated. The fungal growth is evaluated after 14 days. Although it cannot be quantitatively evaluated, the growth on the specimen surface is observed, and the results are reported as No growth, Microscopic growth, or Macroscopic growth.
"The information contained in the article is released by LG Electronics and may not be used for personal work. It may not be copied, reproduced, modified, decompiled, or reverse-engineered into any other work without prior permission from LG Electronics."
*Products and solutions may vary according to country and operating conditions.
Our LGE experts are here to help you. Get in touch with us via the CONTACT US button below.
- Previous
- Next